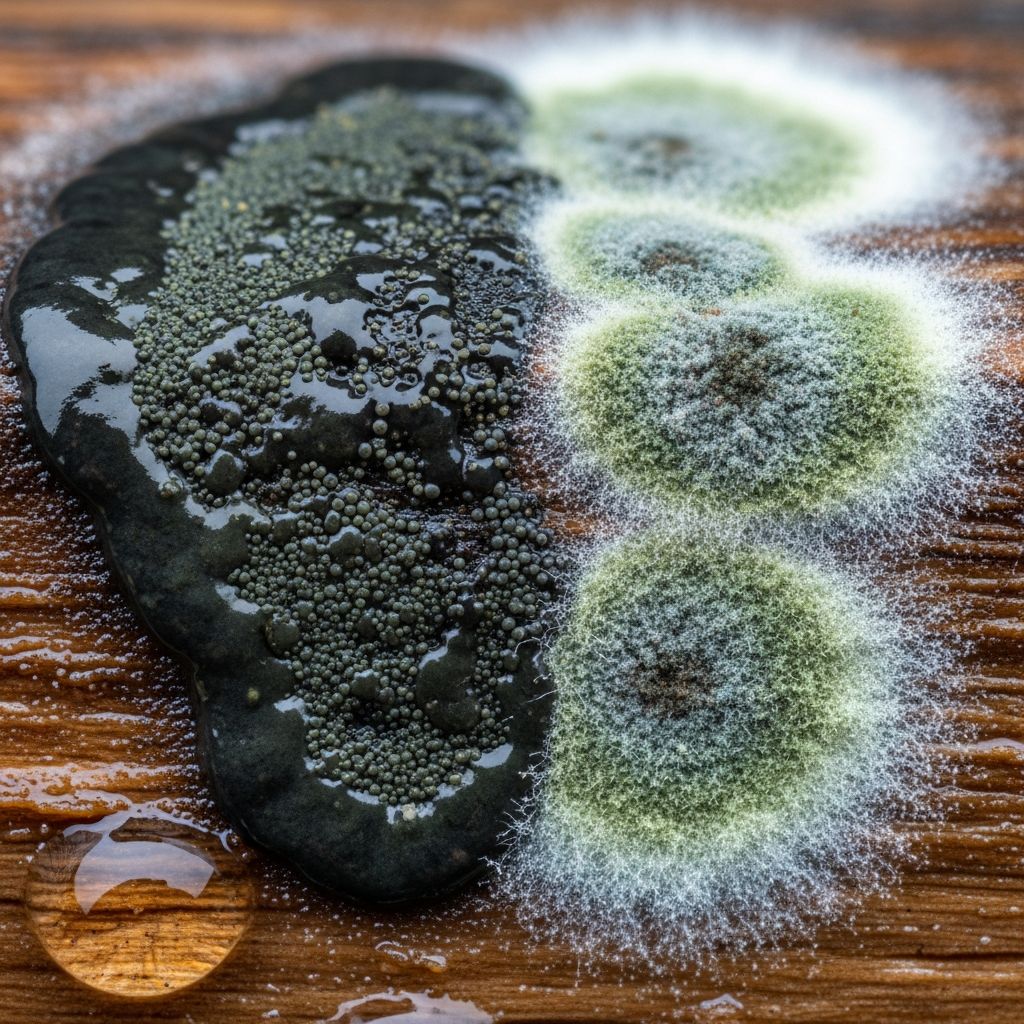
Learn to identify black mold versus regular mold, understand health risks, and discover effective remediation strategies.

Black Mold vs Regular Mold: Key Differences & Health Risks
Learn to identify black mold versus regular mold, understand health risks, and discover effective remediation strategies.
Black Mold vs Regular Mold: Understanding the Critical Differences
Mold is a common problem in many homes, but not all mold is created equal. Understanding the differences between black mold and regular mold is essential for homeowners who want to protect their families’ health and preserve their property. While black mold, scientifically known as Stachybotrys chartarum, often receives significant media attention due to its potential toxicity, regular molds like Aspergillus, Penicillium, and Cladosporium are equally important to address. This comprehensive guide will help you identify, understand, and safely manage both types of mold in your home.
What Is Black Mold?
Black mold, or Stachybotrys chartarum, is a toxic mold species that thrives in environments with excessive moisture and water damage. This mold is particularly dangerous because it produces mycotoxins—toxic substances that can cause serious health problems when inhaled or ingested. Black mold is less common than regular mold varieties, but its presence typically indicates significant moisture problems requiring immediate attention.
The appearance of black mold is distinctive, characterized by a dark greenish-black or jet-black color with a slimy, wet texture. When dry, it may appear rough or crusty. Black mold typically grows in spotty, irregular patterns on affected surfaces.
What Is Regular Mold?
Regular mold encompasses a broad category of mold species that are generally less harmful than black mold. Common types include Penicillium, Aspergillus, and Cladosporium. These molds are more prevalent in homes and can appear in various colors, ranging from white and yellow to green, blue, gray, and brown. While regular molds may still cause health issues, particularly for individuals with allergies or asthma, they typically produce fewer or less potent mycotoxins than black mold.
Regular molds often display fuzzy, powdery, or velvety textures and grow in irregular shapes. They are commonly found on organic materials like food, wood, fabric, and paper in damp environments such as bathrooms and kitchens.
Key Differences Between Black Mold and Regular Mold
Understanding the distinguishing characteristics of black mold and regular mold can help homeowners identify potential problems early and take appropriate action.
| Characteristic | Black Mold | Regular Mold |
|---|---|---|
| Appearance | Dark greenish-black or jet black; slimy when wet | White, yellow, green, blue, gray, or brown; fuzzy or powdery |
| Texture | Slimy or wet texture; rough when dry | Fuzzy, velvety, or powdery texture |
| Growth Environment | Thrives in areas with consistent moisture from water damage | Grows in less severe conditions like bathroom humidity or condensation |
| Odor | Strong, earthy, musty smell; often overwhelming | Mild to moderate odor |
| Toxicity | Produces mycotoxins; highly toxic | Allergenic or pathogenic; less commonly toxic |
| Prevalence | Less common | More common in households |
| Health Risks | Severe respiratory issues, neurological problems, skin irritation | Allergic reactions, asthma exacerbation, mild respiratory issues |
Where Black Mold and Regular Mold Grow
Black Mold Growth Environments
Black mold specifically thrives in environments with extreme moisture and water damage. Its presence almost always indicates a serious, long-standing moisture problem that requires professional remediation. Common locations for black mold include:
– Water-damaged walls and basements- Leaking roofs and ceilings- Poorly ventilated bathrooms with persistent moisture- Flooded areas or properties with water intrusion- Areas around plumbing leaks and condensation issues
Regular Mold Growth Environments
Regular molds are more adaptable and can grow in a wider variety of conditions. They typically appear in moderately damp areas rather than severely water-damaged spaces. Common locations include:
– Bathroom tiles and shower areas- Kitchen surfaces and around sinks- Basements with occasional moisture- Windows with condensation buildup- Poorly ventilated closets and storage areas- Around window frames and door seals
Health Effects and Risks
Black Mold Health Risks
Black mold exposure is particularly concerning due to the mycotoxins it produces. These toxic compounds can cause serious health problems, especially with prolonged exposure. Health effects associated with black mold include:
– Severe respiratory issues including chronic coughing- Shortness of breath and bronchitis- Neurological problems such as memory loss and difficulty concentrating- Chronic headaches and migraines- Skin irritation and rashes- Eye, nose, and throat irritation- Fatigue and weakness- Immune system suppression- In severe cases, neurological damage
Individuals most vulnerable to black mold exposure include children, elderly people, pregnant women, and those with compromised immune systems, allergies, or existing respiratory conditions.
Regular Mold Health Risks
While regular molds are generally less toxic than black mold, they can still cause health problems, particularly for sensitive individuals. Common health effects from regular mold exposure include:
– Allergic reactions such as sneezing and nasal congestion- Itchy or watery eyes- Skin irritation and itching- Mild to moderate respiratory irritation- Asthma flare-ups and exacerbation- Chronic coughing- Sinus congestion- General malaise and discomfort
Long-term exposure to any mold type can accumulate health effects, making prompt removal essential regardless of whether the mold is black or regular varieties.
Identifying Mold in Your Home
Visual Identification
While color can provide a clue, it is not a definitive indicator of mold toxicity. Black mold appears distinctly dark and slimy, whereas regular molds display more variety in color and texture. However, some regular molds can also appear black or very dark, making professional testing important for definitive identification.
Testing and Professional Assessment
The most reliable way to identify mold species is through professional testing. Professionals can collect samples and analyze them in laboratories to determine exactly which mold species is present. This information is crucial for determining appropriate remediation strategies and understanding potential health risks. Never rely solely on appearance to determine mold toxicity—professional testing is the only reliable method.
Mold Prevention Strategies
Controlling Moisture
The most effective mold prevention strategy is controlling moisture in your home. Since both black mold and regular mold require moisture to grow, reducing humidity and eliminating water sources is paramount:
– Install and maintain exhaust fans in bathrooms and kitchens- Ensure proper ventilation throughout your home- Fix leaking pipes and roof leaks promptly- Use dehumidifiers in damp areas- Grade soil away from your home’s foundation- Install proper gutter systems and downspouts- Ensure adequate drainage around your property- Insulate cold pipes to prevent condensation- Maintain indoor humidity between 30-50%
Regular Maintenance and Inspection
Regular home inspections help identify moisture problems before mold develops. Pay particular attention to:
– Basement and crawl spaces- Attics and roof areas- Bathroom and kitchen areas- Areas around windows and doors- Plumbing connections and supply lines- HVAC systems and ductwork
Safe Mold Removal and Remediation
When to Call Professionals
While small areas of regular mold (typically less than 10 square feet) may be manageable with proper precautions and cleaning products, black mold and large mold colonies should always be handled by professional remediation companies. Professional services ensure proper containment, removal, and disposal while protecting your family’s health.
DIY Mold Cleaning for Small Areas
For small areas of regular mold, homeowners can attempt cleaning with proper safety precautions:
– Wear protective equipment including N95 masks, gloves, and eye protection- Ensure proper ventilation by opening windows and using fans- Use diluted bleach solutions or commercial mold cleaners- Never mix bleach with ammonia or other chemicals- Clean thoroughly and allow surfaces to dry completely- Dispose of contaminated materials properly
Professional Remediation Process
Professional mold remediation typically includes:
– Assessment and testing to identify mold species and extent- Containment to prevent spore dispersal- HEPA filtration and air scrubbing- Safe removal of contaminated materials- Cleaning and treatment of affected areas- Addressing underlying moisture problems- Post-remediation testing to verify success
Frequently Asked Questions
Q: How can I tell if mold is black mold?
A: Black mold typically appears dark green or jet black with a slimy texture when wet and rough texture when dry. However, professional testing is the only reliable way to confirm Stachybotrys chartarum presence, as some regular molds can also appear black.
Q: Is all black-colored mold toxic?
A: No. Not all black-colored mold is toxic black mold. Many mold species appear black or dark but are not Stachybotrys chartarum. Toxicity depends on the specific mold species and mycotoxins it produces, not just its color.
Q: Can I clean black mold myself?
A: Black mold should not be cleaned by untrained individuals. Professional remediation is essential to ensure safe removal, proper containment, and protection of your family’s health.
Q: What are the first signs of mold in my home?
A: Look for visible discoloration on walls or ceilings, musty odors, water stains, condensation problems, or signs of water damage. Any of these indicators warrant investigation.
Q: How often should I inspect my home for mold?
A: Conduct visual inspections seasonally and after any water events. Pay special attention to high-risk areas like basements, bathrooms, and areas with previous water damage.
Q: Can mold return after remediation?
A: Yes, if moisture problems are not addressed. Professional remediation addresses both the mold and underlying moisture issues to prevent recurrence.
Q: What should I do if I suspect black mold?
A: Avoid disturbing the area, ensure proper ventilation, and contact a professional mold remediation company immediately for assessment and safe removal.
References
- Black Mold vs. Regular Mold: Understanding the Differences — First & Last Restoration. 2024. https://www.firstandlastrestoration.com/black-mold-vs-regular-mold/
- What’s the Difference Between Black Mold and Regular Mold? — Angi. 2024. https://www.angi.com/articles/black-mold-vs-regular-mold.htm
- The Differences Between Black Mold vs Regular Mold — Reagan Environmental. 2024. https://reaganenvironmental.com/differences-between-black-mold-vs-regular-mold/
- Toxic Black Mold vs. Black Mold — ATI Restoration. 2024. https://atirestoration.com/blog/toxic-black-mold-vs-black-mold/
- Identifying Mold Types: What Colors are Mold and Mildew? — OSHA. 2024. https://www.osha.com/blog/identifying-mold-types
Read full bio of Sneha Tete










